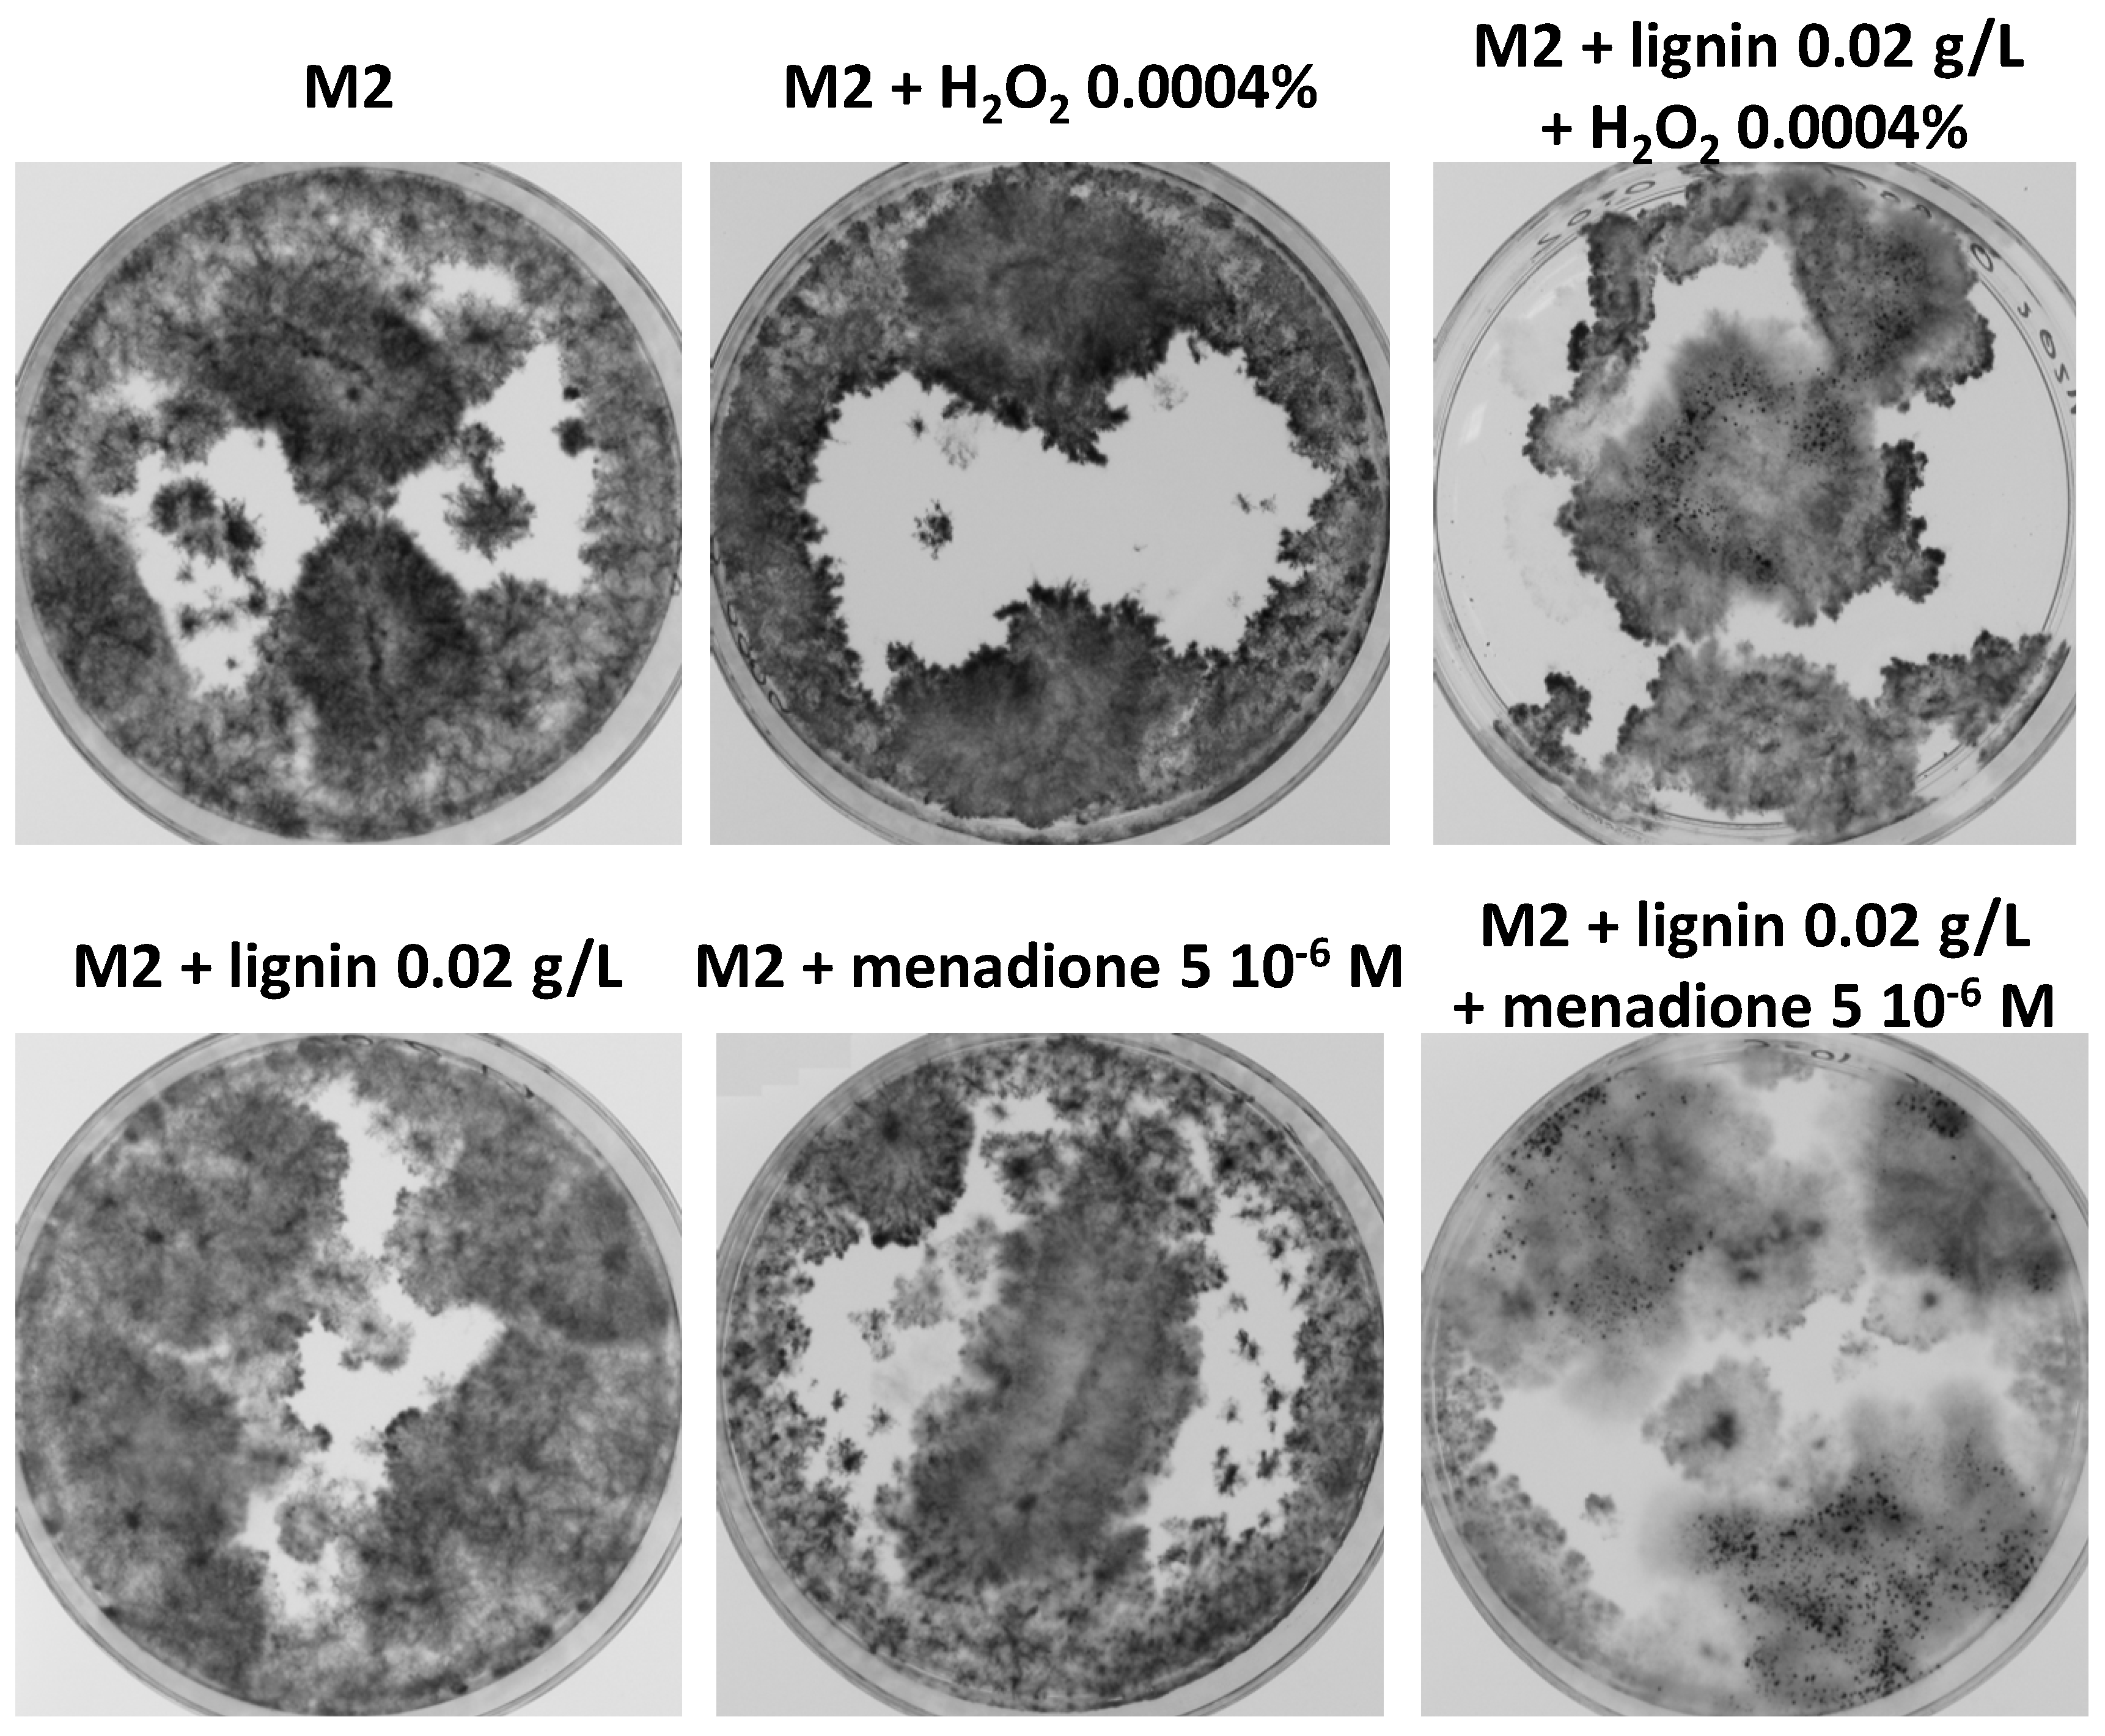
Jof 06 00278 g010 Jof 06 00278 g010

Lignin Degradation and Its Use in Signaling Development by the Coprophilous Ascomycete Podospora anserina
Abstract
1. Introduction
2. Materials and Methods
2.1. Strains, Media and Chemicals
2.2. Growth and Fertility Assays
2.3. Azure B Discoloration and Lignin Transformation Time Course Assays
2.4. UV-Vis Time Course and Fluorescence Time Course Assays
2.5. Determination of Ε-Molar Extinction Coefficient of Lignin
2.6. In Situ Pyrolysis–GCMS Analysis Method
3. Results
3.1. Growth and Fertility of P. anserina on Dung Pellets Is Very Heterogeneous
3.2. P. anserina Is Able to Grow and Fructify on Various Lignocellulose Sources
3.3. Ability of P. anserina to Scavenge Nutrients from Lignocellulose Is Limited by a Developmental Program and Not by Inability to Further Break Down Lignocellulose
3.4. Spectroscopic Analyses Indicate That P. anserina Efficiently Breaks Down Lignin
3.5. Pyrolysis–Gas Chromatography Analyses Confirm That P. anserina Modifies Lignin When Growing on MG
3.6. P. anserina Grows and Fructifies Better in the Presence of Lignin and Oak Extractives
3.7. The CATΔΔΔΔΔ Catalase Mutant Is Able to Grow and Fructify on MG and in Liquid M2
3.8. Oxidative Stress Promotes Growth and Fertility of Liquid Cultures in the Presence of Lignin
3.9. Antioxidants Do Not Inhibit Improved Growth and Fertility by Lignin
3.10. Improved Fertility in the Presence of Lignin Is Also Observed in Chaetomium globosum
4. Discussion
5. Conclusions
Supplementary Materials
Author Contributions
Funding
Acknowledgments
Conflicts of Interest
References
- Pollegioni, L.; Tonin, F.; Rosini, E. Lignin-degrading enzymes. FEBS J. 2015, 282, 1190–1213. [Google Scholar] [CrossRef] [PubMed]
- Levasseur, A.; Drula, E.; Lombard, V.; Coutinho, P.M.; Henrissat, B. Expansion of the enzymatic repertoire of the CAZy database to integrate auxiliary redox enzymes. Biotechnol. Biofuels 2013, 6, 41. [Google Scholar] [CrossRef] [PubMed]
- Arantes, V.; Goodell, B. Current Understanding of Brown-Rot Fungal Biodegradation Mechanisms: A Review. In Deterioration and Protection of Sustainable Biomaterials; American Chemical Society: Washington, DC, USA, 2014; Volume 1158, pp. 3–21. [Google Scholar]
- Moreno, A.D.; Ibarra, D.; Alvira, P.; Tomas-Pejo, E.; Ballesteros, M. A review of biological delignification and detoxification methods for lignocellulosic bioethanol production. Crit. Rev. Biotechnol. 2014, 35, 342–354. [Google Scholar] [CrossRef] [PubMed]
- Dashtban, M.; Schraft, H.; Syed, T.A.; Qin, W. Fungal biodegradation and enzymatic modification of lignin. Int. J. Biochem. Mol. Biol. 2010, 1, 36–50. [Google Scholar] [PubMed]
- Mäkelä, M.R.; Donofrio, N.; De Vries, R.P. Plant biomass degradation by fungi. Fungal Genet. Biol. 2014, 72, 2–9. [Google Scholar] [CrossRef]
- Gupta, V.K.; Kubicek, C.P.; Berrin, J.-G.; Wilson, D.W.; Couturier, M.; Berlin, A.; Filho, E.X.; Ezeji, T. Fungal Enzymes for Bio-Products from Sustainable and Waste Biomass. Trends Biochem. Sci. 2016, 41, 633–645. [Google Scholar] [CrossRef]
- Helmich, K.E.; Pereira, J.H.; Gall, D.L.; Heins, R.A.; McAndrew, R.P.; Bingman, C.A.; Deng, K.; Holland, K.C.; Noguera, D.R.; Simmons, B.A.; et al. Structural Basis of Stereospecificity in the Bacterial Enzymatic Cleavage of β-Aryl Ether Bonds in Lignin. J. Biol. Chem. 2016, 291, 5234–5246. [Google Scholar] [CrossRef]
- Wang, W.; Zhang, C.; Sun, X.; Su, S.; Li, Q.; Linhardt, R.J. Efficient, environmentally-friendly and specific valorization of lignin: Promising role of non-radical lignolytic enzymes. World J. Microbiol. Biotechnol. 2017, 33, 125. [Google Scholar] [CrossRef]
- Martinez, D.; Challacombe, J.; Morgenstern, I.; Hibbett, D.; Schmoll, M.; Kubicek, C.P.; Ferreira, P.; Ruiz-Duenas, F.J.; Martinez, A.T.; Kersten, P.; et al. Genome, transcriptome, and secretome analysis of wood decay fungusPostia placentasupports unique mechanisms of lignocellulose conversion. Proc. Natl. Acad. Sci. USA 2009, 106, 1954–1959. [Google Scholar] [CrossRef]
- Brun, S.; Malagnac, F.; Bidard, F.; Lalucque, H.; Silar, P. Functions and regulation of the Nox family in the filamentous fungusPodospora anserina: A new role in cellulose degradation. Mol. Microbiol. 2009, 74, 480–496. [Google Scholar] [CrossRef]
- Couturier, M.; Tangthirasunun, N.; Ning, X.; Brun, S.; Gautier, V.; Bennati-Granier, C.; Silar, P.; Berrin, J.-G. Plant biomass degrading ability of the coprophilic ascomycete fungus Podospora anserina. Biotechnol. Adv. 2016, 34, 976–983. [Google Scholar] [CrossRef] [PubMed]
- Demoor, A.; Silar, P.; Brun, S. Appressorium: The Breakthrough in Dikarya. J. Fungi 2019, 5, 72. [Google Scholar] [CrossRef] [PubMed]
- Valette, N.; Perrot, T.; Sormani, R.; Gelhaye, E.; Morel-Rouhier, M. Antifungal activities of wood extractives. Fungal Biol. Rev. 2017, 31, 113–123. [Google Scholar] [CrossRef]
- Liers, C.; Ullrich, R.; Steffen, K.T.; Hatakka, A.; Hofrichter, M. Mineralization of 14C-labelled synthetic lignin and extracellular enzyme activities of the wood-colonizing ascomycetes Xylaria hypoxylon and Xylaria polymorpha. Appl. Microbiol. Biotechnol. 2005, 69, 573–579. [Google Scholar] [CrossRef]
- Rodríguez, A.; Carnicero, A.; Perestelo, F.; De La Fuente, G.; Milstein, O.; Falcón, M.A. Effect of Penicillium chrysogenum on Lignin Transformation. Appl. Environ. Microbiol. 1994, 60, 2971–2976. [Google Scholar] [CrossRef]
- Rodríguez, A.; Falcon, M.A.; Carnicero, A.; Perestelo, F.; De La Fuente, G.; Trojanowski, J. Laccase activities of Penicillium chrysogenum in relation to lignin degradation. Appl. Microbiol. Biotechnol. 1996, 45, 399–403. [Google Scholar] [CrossRef]
- Barapatre, A.; Jha, H. Degradation of alkali lignin by two ascomycetes and free radical scavenging activity of the products. Biocatal. Biotransform. 2017, 35, 269–286. [Google Scholar] [CrossRef]
- Regalado, V.; Rodriguez, A.; Perestelo, F.; Carnicero, A.; De La Fuente, G.; Falcon, M.A. Lignin Degradation and Modification by the Soil-Inhabiting Fungus Fusarium proliferatum. Appl. Environ. Microbiol. 1997, 63, 3716–3718. [Google Scholar] [CrossRef]
- Anderson, A.J.; Kwon, S.-I.; Carnicero, A.; Falcón, M.A. Two isolates ofFusarium proliferatumfrom different habitats and global locations have similar abilities to degrade lignin. FEMS Microbiol. Lett. 2005, 249, 149–155. [Google Scholar] [CrossRef]
- Lozovaya, V.V.; Lygin, A.V.; Zernova, O.V.; Li, S.; Widholm, J.M.; Hartman, G.L. Lignin Degradation by Fusarium solani f. sp. glycines. Plant Dis. 2006, 90, 77–82. [Google Scholar] [CrossRef]
- Bi, R.; Huang, S.; Henriksson, G. Isolation of exceedingly low oxygen consuming fungal strains able to utilize lignin as carbon source. Cellul. Chem. Technol. 2016, 50, 811–817. [Google Scholar]
- Bi, R.; Spadiut, O.; Brumer, H.; Henriksson, G. Isolation and identification of microorganisms from soil able to live on lignin as a carbon source and to produce enzymes which cleave the β-o-4 bond in a lignin model compound. Cellul. Chem. Technol. 2012, 46, 227–242. [Google Scholar]
- Bi, R.; Lawoko, M.; Henriksson, G. Phoma herbarum, a soil fungus able to grow on natural lignin and synthetic lignin (DHP) as sole carbon source and cause lignin degradation. J. Ind. Microbiol. Biotechnol. 2016, 43, 1175–1182. [Google Scholar] [CrossRef] [PubMed]
- Espagne, E.; Lespinet, O.; Malagnac, F.; Da Silva, C.; Jaillon, O.; Porcel, B.M.; Couloux, A.; Aury, J.-M.; Ségurens, B.; Poulain, J.; et al. The genome sequence of the model ascomycete fungus Podospora anserina. Genome Biol. 2008, 9, R77. [Google Scholar] [CrossRef] [PubMed]
- Silar, P. Podospora anserina: From laboratory to biotechnology. In Genomics of Soil- and Plant-Associated Fungi; Benjamin, A., Horwitz, P.K.M., Christian, M.M., Kubicek, P., Eds.; Springer: Heidelberg, Germany; New York, NY, USA; Dordrecht, The Netherlands; London, UK, 2013; pp. 283–309. [Google Scholar]
- Bourdais, A.; Bidard, F.; Zickler, D.; Berteaux-Lecellier, V.; Silar, P.; Espagne, E. Wood Utilization Is Dependent on Catalase Activities in the Filamentous Fungus Podospora anserina. PLoS ONE 2012, 7, e29820. [Google Scholar] [CrossRef]
- Tangthirasunun, N.; Navarro, D.; Garajova, S.; Chevret, D.; Tong, L.C.H.; Gautier, V.; Hyde, K.D.; Silar, P.; Berrin, J.G. Inactivation of Podospora anserina cellobiose dehydrogenases modifies its cellulose degradation mechanism. Appl. Environ. Microbiol. 2016, 83, e02716. [Google Scholar] [CrossRef]
- Van Erven, G.; Kleijn, A.F.; Patyshakuliyeva, A.; Di Falco, M.; Tsang, A.; De Vries, R.P.; Van Berkel, W.J.H.; Kabel, M.A. Evidence for ligninolytic activity of the ascomycete fungus Podospora anserina. Biotechnol. Biofuels 2020, 13, 1–12. [Google Scholar] [CrossRef]
- Rizet, G.; Delannoy, G. Sur la production par des hétérozygotes monofactoriels de Podospora anserina de gamétophytes phénotypiquement différents des gamétophytes parentaux. Comptes Rendus Acad. Sci. Paris 1950, 231, 588–590. [Google Scholar]
- Grognet, P.; Bidard, F.; Kuchly, C.; Tong, L.C.; Coppin, E.; Benkhali, J.A.; Couloux, A.; Wincker, P.; Debuchy, R.; Silar, P. Maintaining Two Mating Types: Structure of the Mating Type Locus and Its Role in Heterokaryosis in Podospora anserina. Genetics 2014, 197, 421–432. [Google Scholar] [CrossRef]
- Rizet, G.; Engelmann, C. Contribution à l’étude génétique d’un Ascomycète tétrasporé: Podospora anserina (Ces.). Rehm. Rev. Cytol. Biol. Végétale 1949, 11, 201–304. [Google Scholar]
- Silar, P. Podospora anserina. 2020. HAL (Villeurbanne, France). Available online: https://hal.archives-ouvertes.fr/hal-02475488 (accessed on 15 October 2020).
- Monsigny, L.; Feghali, E.; Berthet, J.-C.; Cantat, T. Efficient reductive depolymerization of hardwood and softwood lignins with Brookhart’s iridium(iii) catalyst and hydrosilanes. Green Chem. 2018, 20, 1981–1986. [Google Scholar] [CrossRef]
- Jakab, E.; Faix, O.; Till, F.; Székely, T. Thermogravimetry/mass spectrometry study of six lignins within the scope of an international round robin test. J. Anal. Appl. Pyrolysis 1995, 35, 167–179. [Google Scholar] [CrossRef]
- Shen, D.; Gu, S.; Luo, K.; Wang, S.; Fang, M. The pyrolytic degradation of wood-derived lignin from pulping process. Bioresour. Technol. 2010, 101, 6136–6146. [Google Scholar] [CrossRef] [PubMed]
- Nakamura, T.; Kawamoto, H.; Saka, S. Pyrolysis behavior of Japanese cedar wood lignin studied with various model dimers. J. Anal. Appl. Pyrolysis 2008, 81, 173–182. [Google Scholar] [CrossRef]
- Melkior, T.; Jacob, S.; Gerbaud, G.; Hediger, S.; Pape, L.; Bonnefois, L.; Bardet, M. NMR analysis of the transformation of wood constituents by torrefaction. Fuel 2012, 92, 271–280. [Google Scholar] [CrossRef]
- Candelier, K.; Chaouch, M.; Dumarçay, S.; Pétrissans, A.; Pétrissans, M.; Gérardin, P. Utilization of thermodesorption coupled to GC–MS to study stability of different wood species to thermodegradation. J. Anal. Appl. Pyrolysis 2011, 92, 376–383. [Google Scholar] [CrossRef]
- Cao, J.; Xiao, G.; Xu, X.; Shen, D.; Jin, B. Study on carbonization of lignin by TG-FTIR and high-temperature carbonization reactor. Fuel Process. Technol. 2013, 106, 41–47. [Google Scholar] [CrossRef]
- Monteil-Rivera, F.; Phuong, M.; Ye, M.; Halasz, A.; Al-Hawari, J. Isolation and characterization of herbaceous lignins for applications in biomaterials. Ind. Crops Prod. 2013, 41, 356–364. [Google Scholar] [CrossRef]
- Faravelli, T.; Frassoldati, A.; Migliavacca, G.; Ranzi, E. Detailed kinetic modeling of the thermal degradation of lignins. Biomass Bioenergy 2010, 34, 290–301. [Google Scholar] [CrossRef]
- Worrall, J.J.; Anagnost, S.E.; Zabel, R.A. Comparison of wood decay among diverse lignicolous fungi. Mycologia 1997, 199–219. [Google Scholar] [CrossRef]
- Archibald, F.S. A new assay for lignin-type peroxidases employing the dye azure B. Appl. Environ. Microbiol. 1992, 58, 3110–3116. [Google Scholar] [CrossRef]
- Levin, L.; Papinutti, L.; Forchiassin, F. Evaluation of Argentinean white rot fungi for their ability to produce lignin-modifying enzymes and decolorize industrial dyes. Bioresour. Technol. 2004, 94, 169–176. [Google Scholar] [CrossRef] [PubMed]
- Chen, K.; Cao, M.; Ding, C.; Zheng, X. A green approach for the synthesis of novel Ag 3 PO 4/SnO 2/porcine bone and its exploitation as a catalyst in the photodegradation of lignosulfonate into alkyl acids. RSC Adv. 2018, 8, 26782–26792. [Google Scholar] [CrossRef]
- Yuan, X.; Tian, G.; Zhao, Y.; Zhao, L.; Wang, H.; Ng, T.B. Degradation of dyes using crude extract and a thermostable and pH-stable laccase isolated from Pleurotus nebrodensis. Biosci. Rep. 2016, 36, e00365. [Google Scholar] [CrossRef]
- Barsberg, S.; Elder, T.; Felby, C. Lignin−Quinone Interactions: Implications for Optical Properties of Lignin. Chem. Mater. 2003, 15, 649–655. [Google Scholar] [CrossRef]
- Machado, A.E.; Furuyama, A.M.; Falone, S.Z.; Ruggiero, R.; Perez, D.D.S.; Castellan, A. Photocatalytic degradation of lignin and lignin models, using titanium dioxide: The role of the hydroxyl radical. Chemosphere 2000, 40, 115–124. [Google Scholar] [CrossRef]
- Irbe, I.; Noldt, G.; Koch, G.; Andersone, I.; Andersons, B. Application of scanning UV microspectrophotometry for the topochemical detection of lignin within individual cell walls of brown-rotted Scots pine (Pinus sylvestris L.) sapwood. Holzforschung 2006, 60, 601–607. [Google Scholar] [CrossRef]
- Lourenço, A.; Gominho, J.; Marques, A.V.; Pereira, H. Comparison of Py-GC/FID and Wet Chemistry Analysis for Lignin Determination in Wood and Pulps from Eucalyptus globulus. Bioresources 2013, 8, 2967–2980. [Google Scholar] [CrossRef]
- Arias, M.E.; Rodríguez, J.; Pérez, M.I.; Hernández, M.; Polvillo, O.; González-Pérez, J.A.; González-Vila, F.J. Analysis of chemical changes in Picea abies wood decayed by different Streptomyces strains showing evidence for biopulping procedures. Wood Sci. Technol. 2009, 44, 179–188. [Google Scholar] [CrossRef]
- Arias, M.; Blánquez, A.; Hernández, M.; Rodríguez, J.; Ball, A.S.; Morillo, N.T.J.; González-Vila, F.J.; González-Pérez, J.A. Role of a thermostable laccase produced by Streptomyces ipomoeae in the degradation of wheat straw lignin in solid state fermentation. J. Anal. Appl. Pyrolysis 2016, 122, 202–208. [Google Scholar] [CrossRef]
- Rouches, E.; Dignac, M.-F.; Zhou, S.; Carrere, H. Pyrolysis-GC–MS to assess the fungal pretreatment efficiency for wheat straw anaerobic digestion. J. Anal. Appl. Pyrolysis 2017, 123, 409–418. [Google Scholar] [CrossRef]
- Laskar, D.D.; Ke, J.; Zeng, J.; Gao, X.; Chen, S. Py-GC/MS as a Powerful and Rapid Tool for Determining Lignin Compositional and Structural Changes in Biological Processes. Curr. Anal. Chem. 2013, 9, 335–351. [Google Scholar] [CrossRef]
- Collard, F.-X.; Blin, J. A review on pyrolysis of biomass constituents: Mechanisms and composition of the products obtained from the conversion of cellulose, hemicelluloses and lignin. Renew. Sustain. Energy Rev. 2014, 38, 594–608. [Google Scholar] [CrossRef]
- El Fels, L.; Lemee, L.; Ambles, A.; Hafidi, M. Identification and biotransformation of lignin compounds during co-composting of sewage sludge-palm tree waste using pyrolysis-GC/MS. Int. Biodeterior. Biodegrad. 2014, 92, 26–35. [Google Scholar] [CrossRef]
- Otsuka, Y.; Sonoki, T.; Ikeda, S.; Kajita, S.; Nakamura, M.; Katayama, Y. Detection and characterization of a novel extracellular fungal enzyme that catalyzes the specific and hydrolytic cleavage of lignin guaiacylglycerol beta-aryl ether linkages. JBIC J. Biol. Inorg. Chem. 2003, 270, 2353–2362. [Google Scholar] [CrossRef]
- Xu, Z.; Zhang, D.; Hu, J.; Zhou, X.; Ye, X.; Reichel, K.L.; Stewart, N.R.; Syrenne, R.D.; Yang, X.; Gao, P.; et al. Comparative genome analysis of lignin biosynthesis gene families across the plant kingdom. BMC Bioinform. 2009, 10, S3. [Google Scholar] [CrossRef] [PubMed]
- Pattathil, S.; Hahn, M.G.; Dale, B.E.; Chundawat, S.P.S. Insights into plant cell wall structure, architecture, and integrity using glycome profiling of native and AFEXTM-pre-treated biomass. J. Exp. Bot. 2015, 66, 4279–4294. [Google Scholar] [CrossRef][Green Version]
- Garcia, A.; Amendola, D.; González, M.; Spigno, G.; Labidi, J. Lignin as natural radical scavenger. Study of the antioxidant capacity of apple tree pruning lignin obtained by different methods. Chem. Eng. Trans. 2011, 24, 925–931. [Google Scholar]
- Gülçin, I.; Huyut, Z.; Elmastaş, M.; Aboul-Enein, H.Y. Radical scavenging and antioxidant activity of tannic acid. Arab. J. Chem. 2010, 3, 43–53. [Google Scholar] [CrossRef]
- Efimova, I.V.; Khil’Ko, S.L.; Smirnova, O.V. Antioxidant activity of humic acids in radical-chain oxidation processes. Russ. J. Appl. Chem. 2012, 85, 1351–1354. [Google Scholar] [CrossRef]
- Ponomarenko, J.; Lauberts, M.; Dizhbite, T.; Lauberte, L.; Jurkjane, V.; Telysheva, G. Antioxidant activity of various lignins and lignin-related phenylpropanoid units with high and low molecular weight. Holzforschung 2015, 69, 795–805. [Google Scholar] [CrossRef]
- Tai, A.; Sawano, T.; Yazama, F. Antioxidant Properties of Ethyl Vanillinin Vitroandin Vivo. Biosci. Biotechnol. Biochem. 2011, 75, 2346–2350. [Google Scholar] [CrossRef]
- Golumbic, C.; Mattill, H.A. The antioxidant properties of gallic acid and allied compounds. J. Am. Oil Chem. Soc. 1942, 19, 144–145. [Google Scholar] [CrossRef]
- Mäkelä, M.R.; Bredeweg, E.L.; Magnuson, J.K.; Baker, S.E.; De Vries, R.P.; Hildén, K.S. Fungal Ligninolytic Enzymes and Their Applications. Fungal Kingdom 2017, 1049–1061. [Google Scholar] [CrossRef]
- Andlar, M.; Rezić, T.; Marđetko, N.; Kracher, D.; Ludwig, R.; Šantek, B. Lignocellulose degradation: An overview of fungi and fungal enzymes involved in lignocellulose degradation. Eng. Life Sci. 2018, 18, 768–778. [Google Scholar] [CrossRef]
- Egidi, E.; Delgado-Baquerizo, M.; Plett, J.M.; Wang, J.; Eldridge, D.J.; Bardgett, R.D.; Maestre, F.T.; Singh, B.K. A few Ascomycota taxa dominate soil fungal communities worldwide. Nat. Commun. 2019, 10, 1–9. [Google Scholar] [CrossRef]
- Benocci, T.; Daly, P.; Aguilar-Pontes, M.V.; Lail, K.; Wang, M.; Lipzen, A.; Ng, V.; Grigoriev, I.V.; De Vries, R. Enzymatic Adaptation of Podospora anserina to Different Plant Biomass Provides Leads to Optimized Commercial Enzyme Cocktails. Biotechnol. J. 2018, 14, e1800185. [Google Scholar] [CrossRef]
- Mäkelä, M.R.; Bouzid, O.; Robl, D.; Post, H.; Peng, M.; Heck, A.; Altelaar, M.; De Vries, R.P. Cultivation of Podospora anserina on soybean hulls results in an efficient enzyme cocktail for plant biomass hydrolysis. New Biotechnol. 2017, 37, 162–171. [Google Scholar] [CrossRef]
- Xie, N.; Ruprich-Robert, G.; Silar, P.; Chapeland-Leclerc, F. Bilirubin oxidase-like proteins fromPodospora anserina: Promising thermostable enzymes for application in transformation of plant biomass. Environ. Microbiol. 2014, 17, 866–875. [Google Scholar] [CrossRef]
- Xie, N.; Chapeland-Leclerc, F.; Silar, P.; Ruprich-Robert, G. Systematic gene deletions evidences that laccases are involved in several stages of wood degradation in the filamentous fungusPodospora anserina. Environ. Microbiol. 2013, 16, 141–161. [Google Scholar] [CrossRef]
- Benocci, T.; De Vries, R.P.; Daly, P. A senescence-delaying pre-culture medium for transcriptomics of Podospora anserina. J. Microbiol. Methods 2018, 146, 33–36. [Google Scholar] [CrossRef] [PubMed]
- Kawamura, N.; Goto, M.; Nakamura, Y. Effect of lignin and its precursors on végétative growth and fruiting body formation in Lentinus edodes. Trans. Mycol. Soc. Jpn. 1983, 24, 213–222. [Google Scholar]
- Jacobs, S.E.; Marsden, A.W. The role of antibiotics in the decomposition of sawdust: I. Inhibition of the growth of cellulose-decomposing bacteria. Ann. Appl. Biol. 1947, 34, 276–285. [Google Scholar] [CrossRef] [PubMed]
- Brunow, G.; Lundquist, K. Functional groups and bonding patterns in lignin (including the lignin-carbohydrate complexes. In Lignin and Lignans: Advances in Chemistry; Heitner, C., Dimmel, D., Schmidt, J., Eds.; CRC Press: Boca Raton, FL, USA, 2010; pp. 267–299. [Google Scholar]
- Bauer, S.; Sorek, H.; Mitchell, V.D.; Ibáñez, A.B.; Wemmer, D.E. Characterization of Miscanthus giganteus Lignin Isolated by Ethanol Organosolv Process under Reflux Condition. J. Agric. Food Chem. 2012, 60, 8203–8212. [Google Scholar] [CrossRef] [PubMed]
- Brosse, N.; Dufour, A.; Meng, X.; Sun, Q.; Ragauskas, A.J. Miscanthus: A fast-growing crop for biofuels and chemicals production. Biofuels Bioprod. Biorefining 2012, 6, 580–598. [Google Scholar] [CrossRef]
- Reiter, J.; Strittmatter, H.; Wiemann, L.O.; Schieder, D.; Sieber, V. Enzymatic cleavage of lignin β-O-4 aryl ether bonds via net internal hydrogen transfer. Green Chem. 2013, 15, 1373–1381. [Google Scholar] [CrossRef]
- Rosini, E.; Allegretti, C.; Melis, R.; Cerioli, L.; Conti, G.; Pollegioni, L.; D’Arrigo, P. Cascade enzymatic cleavage of the β-O-4 linkage in a lignin model compound. Catal. Sci. Technol. 2016, 6, 2195–2205. [Google Scholar] [CrossRef]
- Morel, M.; Ngadin, A.A.; Droux, M.; Jacquot, J.-P.; Gelhaye, E. The fungal glutathione S-transferase system. Evidence of new classes in the wood-degrading basidiomycete Phanerochaete chrysosporium. Cell. Mol. Life Sci. 2009, 66, 3711–3725. [Google Scholar] [CrossRef]

| Powdered MG | Control MG Raw | S1 | S2 | S3 | S4 | S5 |
|---|---|---|---|---|---|---|
| Group of compounds | ||||||
| furanics | 16.7% | - | + | - | + | + |
| phenolics Cn < 3 | 17.5% | + | + | ++ | ++ | ++ |
| phenolics C3 | 5.3% | - | = | = | = | ++ |
| total phenolics | 22.8% | + | + | ++ | ++ | ++ |
| other lignin derived compounds | 5.6% | = | - | - | -- | -- |
| anhydrous sugars | 6.4% | - | - | - | - | -- |
| linear compounds | 40.2% | - | -- | - | - | - |
| cyclic compounds | 8.4% | ++ | ++ | + | ++ | ++ |
| acetic acid | 16.3 | - | - | - | - | -- |
| Fragmented MG | Control MG Raw | S1 | S2 | S3 | S4 | S5 |
|---|---|---|---|---|---|---|
| Group of compounds | ||||||
| furanics | 14.9% | = | + | -- | -- | = |
| phenolics Cn < 3 | 18.4% | ++ | ++ | + | ++ | ++ |
| phenolics C3 | 3.9% | - | = | ++ | - | = |
| total phenolics | 22.3% | + | ++ | ++ | ++ | ++ |
| other lignin derived compounds | 3.2% | ++ | = | + | ++ | -- |
| anhydrous sugars | 4.6% | - | - | = | -- | - |
| linear compounds | 44.7% | -- | -- | -- | -- | - |
| cyclic compounds | 10.2% | ++ | ++ | ++ | ++ | ++ |
| acetic acid | 15.7% | -- | -- | -- | -- | - |
Publisher’s Note: MDPI stays neutral with regard to jurisdictional claims in published maps and institutional affiliations. |
© 2020 by the authors. Licensee MDPI, Basel, Switzerland. This article is an open access article distributed under the terms and conditions of the Creative Commons Attribution (CC BY) license (http://creativecommons.org/licenses/by/4.0/).
Share and Cite
Dicko, M.; Ferrari, R.; Tangthirasunun, N.; Gautier, V.; Lalanne, C.; Lamari, F.; Silar, P. Lignin Degradation and Its Use in Signaling Development by the Coprophilous Ascomycete Podospora anserina. J. Fungi 2020, 6, 278. https://doi.org/10.3390/jof6040278
Dicko M, Ferrari R, Tangthirasunun N, Gautier V, Lalanne C, Lamari F, Silar P. Lignin Degradation and Its Use in Signaling Development by the Coprophilous Ascomycete Podospora anserina. Journal of Fungi. 2020; 6(4):278. https://doi.org/10.3390/jof6040278
Chicago/Turabian StyleDicko, Moussa, Roselyne Ferrari, Narumon Tangthirasunun, Valérie Gautier, Christophe Lalanne, Farida Lamari, and Philippe Silar. 2020. "Lignin Degradation and Its Use in Signaling Development by the Coprophilous Ascomycete Podospora anserina" Journal of Fungi 6, no. 4: 278. https://doi.org/10.3390/jof6040278
APA StyleDicko, M., Ferrari, R., Tangthirasunun, N., Gautier, V., Lalanne, C., Lamari, F., & Silar, P. (2020). Lignin Degradation and Its Use in Signaling Development by the Coprophilous Ascomycete Podospora anserina. Journal of Fungi, 6(4), 278. https://doi.org/10.3390/jof6040278

